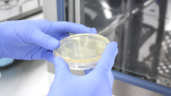
05

MOLEKÜLER BİYOLOJİ ve GENETİK LABORATUVARIMIZ
Bir tanesi Bilkent Cyberpark’ta diğer ikisi İvedik Organize Sanayi Bölgesi’ndeki fabrikamızda olmak üzere 3 adet biyoteknoloji laboratuvarına sahip olan Eryiğit, sentetik biyoloji ve biyoteknolojinin çeşitli alanlarında Ar-Ge projeleri yapmaya ve geliştirdiği ürünleri ticarileştirmeye devam etmektedir. İvedik OSB bölgesindeki laboratuvarlarımızdan biri Ar-Ge amaçlı kullanılan 200 m2 genişliğinde bir Moleküler Biyoloji laboratuvarı olup içesinde genel moleküler biyoloji, hücre kültürü, 2 adet mikrobiyoloji ve maya kültürü laboratuvarları bulunmaktadır. 400 m2 genişliğindeki diğer laboratuvarımız ise temiz oda özelliğine sahip olup GMP üretim gerçekleştirmektedir.
MOLEKÜLER BİYOLOJİ ve GENETİK LABORATUVARIMIZ

Ürünlerimizle İlgili yapılan testler ve Ar-Ge çalışmalarımız, laboratuvarımızda titizlikle yapılıp analizleri çıkartılmaktadır.